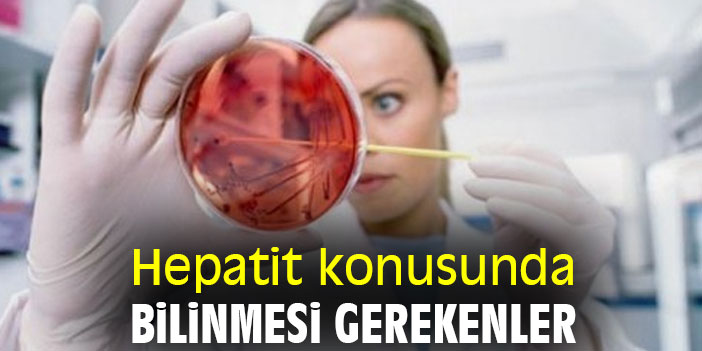

Hepatit konusunda bilinmesi gerekenler
DoktorTakvimi uzmanlarından İç Hastalıkları Uzm. Dr. Tuğba Taşcı, hepatiti önlemeye ilişkin sağlıklı beslenme, hijyen ve aşı konularında açıklamalarda bulundu.
DoktorTakvimi uzmanlarından İç Hastalıkları Uzm. Dr. Tuğba Taşcı, hepatit bir belirti göstermeden ortaya çıkabileceğini ama çoğu zaman sarılık, iştahsızlık, halsizlik gibi semptomlarla kendini gösterdiğini belirtiyor.
Hepatit en fazla viral etkenlerle ortaya çıkıyor
Karaciğerimiz sindirim sisteminden kana geçen çoğu madde için süzgeç görevi görür. Kana karışan bu maddeler vücudumuz için gerekli temel parçacıklara ya ayrıştırılır ya da fonksiyonel hale getirilir. Bu yapıtaşlarından bazılarını depolama görevi de vardır. Zararlı maddelerin detoksifikasyon yoluyla vücuttan uzaklaşmasını sağlar. Aynı zamanda safra asitlerini sentezleyerek besinlerle aldığımız yağların ve yağda eriyen vitaminlerin emilmesini kolaylaştırır. Karaciğer dokusunda iltihaplanma olduğunda tüm bu fonksiyonların etkilendiğini söyleyen Uzm. Dr. Taşcı, hepatitin en fazla viral etkenlerle ortaya çıktığını hatırlatıyor.

Hepatit A ve E’nin yediklerimizle ya da tuvalet yoluyla bulaşabildiğini belirten Taşçı, “B, C, D ve G ise kan yoluyla ya da vücut sıvılarıyla bulaşabilir. Koruyucu önlemlere dikkat etmek çok önemlidir çünkü hepatit B, C, D ve G kronikleşerek siroza sebep olabilir. 6 aydan uzun süren hepatit tablosuna kronik hepatit denilir. Günümüzde sıklığı artan nonalkolik steatohepatit ise önce karaciğerde yağlanma olarak bilinen nonalkolik karaciğer yağlanması şeklinde başlar. Bu durum abdominal obezite , yağlı ve fruktozdan (meyve şekeri) zengin beslenme, tip 2 diyabet ve insülin direnci, kolesterol yüksekliği, hareketsiz yaşam ve daha da önemlisi bağırsak florasının bozulması nedeniyle oluşur.” dedi.
Früktozdan zengin beslenme siroza sebep olabiliyor
DoktorTakvimi uzmanlarından İç Hastalıkları Uzm. Dr. Taşçı, früktozdan zengin beslenmenin bağırsak mikrobiyotasını değiştirerek karaciğer yağlanmasıyla çok yakın ilişkili olduğu belirterek bu durumu“Früktozdan zengin beslenmede bağırsak duvarı giderek zedelenir. Aynı zamanda oluşan insülin direnci ile ince bağırsak florası değişir. Oluşan bakteriyel toksinler bağırsak duvarından kana karışır ve ilk olarak karaciğere gider. Burada inflamasyon tetiklenir ve yağlı karaciğere zemin hazırlar. Müdahale edilmez ise ilerleyerek dokuda fibroz doku oluşumu ve siroza kadar ilerler.” sözleriyle açıkladı.
Uzm. Dr. Taşcı, genel olarak hepatiti önlemek için “Sağlıklı beslenmeye özen gösterin. Şeker alımını azaltın, sebze ağırlıklı ve sağlıklı yağlardan zengin beslenin. Alkol alımını bırakın. Toksik maddelerden paketlenmiş ürünlerden uzak durun, bitkisel takviyelere dikkat edin. Kişisel koruyucu önlemlerimizi artırın, Hepatit B aşısı yaptırın. Egzersize önem verin ve sürekli hale getirin.” önerilerinde bulundu.










Türkçe karakter kullanılmayan ve büyük harflerle yazılmış yorumlar onaylanmamaktadır.